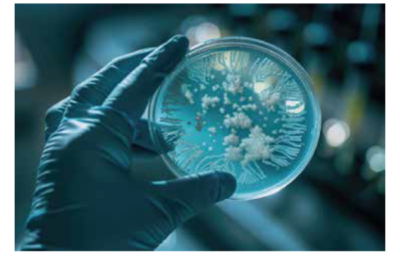

-

Qualidade do Ambiente Interno
Ar-condicionado como aliado da qualidade dos ambientes internos
Sensação de que o ar-condicionado “faz mal” pode ser reforçada pela exposição prolongada a ambientes fechados e …
-

Climatização
Como a Inteligência Artificial pode enriquecer a prática no AVAC-R
Ferramenta libera o profissional do trabalho bruto e repetitivo, permitindo que ele se concentre no que realmente …
-

Ventilação e Exaustão
Dutos: aplicações e recomendações
Os dutos de aço galvanizado atendem à grande maioria das instalações, desde que obedecidas as normas de …
-

Climatização
Escolha do duto impacta o desempenho e a sustentabilidade
Escolha é um dos fatores mais críticos para o desempenho da instalação, influenciando o fluxo de …
-

Energia e Meio Ambiente
Estratégias avançadas para a sustentabilidade no AVAC-R
Tudo começa com um projeto bem elaborado, no qual o projetista de AVAC é envolvido desde …
-

Ventilação e Exaustão
Caminhos para reduzir consumo de energia em sistemas de ventilação e distribuição do ar
Eficiência energética é um quebra-cabeça no qual todas as peças precisam se encaixar perfeitamente A busca pela …
-

Qualidade do Ambiente Interno
Estratégias para redução do consumo de água
Redução do consumo de água representa uma convergência vantajosa entre sustentabilidade ambiental e eficiência operacional Em um …
-
Qualidade do Ambiente Interno
Doença dos legionários
Legionellose é o termo usado para infecções causas pela bactéria Legionellapneumophila e outras bactérias da família Legionellacea …
-

Energia e Meio Ambiente
Descarbonização, eficiência energética e qualidade do ar interior
Tendências apontam para um futuro em que os sistemas serão não apenas mais eficientes, mas também mais …
-

Mercado
Munters comemora 70 anos de história e 30 no Brasil
A Munters, que está celebrando 70 anos de história, iniciou suatrajetória em 1955, com o inventor sueco …
-

Ventilação e Exaustão
Estratégias de ventilação mecânica para conforto e produtividade em conformidade com a NR-17
Em ambientes industriais, onde máquinas rugem, processos de calor intenso operam continuamente e a radiação solar incide …
-

Mercado
Destaques do ano exalta inovação, eficiência energética e qualidade do ar interior
Em sua 31ª. edição, o “Prêmio Destaques do Ano Smacna Brasil” consagrou 6 instalações. A entrega do …
-

Cursos e Treinamentos
Entrac encerra a programação de 2025 em Belo Horizonte
Encontro Tecnológico de Refrigeração e Ar-Condicionado visitou, além de BH, as cidades de Brasília, Natal, Porto Alegre …
-

Projeto e Consultoria
O papel estratégico do projeto de sistemas de climatização em cozinhas profissionais
A climatização e a ventilação de cozinhas profissionais são áreas em que a engenharia exerce papel fundamental …
-

Mercado
Conbrava 2025 destacou sustentabilidade e inovação
A 19ª edição do Conbrava (Congresso Brasileiro de Refrigeração, Ar Condicionado, Ventilação, Aquecimento e Tratamento de Ar), …
-

Projeto e Consultoria
Presença recorde na 25ª edição do ENPC
Cerca de 430 profissionais estiveram presentes nos dias 8 e 9 de setembro na 25ª edição do …
-

Qualidade do Ambiente Interno
Mesa-redonda de qualidade do ar interno
A importância da qualidade do ar interior (QAI) e os meios para sua efetiva implementação técnica foram …
-

Mercado
Protagonismo da Abrava durante a Febrava 2025
Entidade capitaneou as iniciativas desenvolvidas pelo setor AVACR, movimentando o mercado, não só brasileiro, como latinoamericano A …
-

Meio Ambiente
Mesa-redonda derruba mitos e reforça urgência da gestão hídrica
Coordenada por Anderson Doms, ex-presidente do Departamento Nacional de Tratamento de Águas da Abrava, a mesa-redonda contou …
-

Mercado
31º Prêmio Destaques do Ano Smacna Brasil contempla seis obras
Aos 31 anos de idade, o Prêmio Destaques do Ano Smacna Brasil contabiliza, com as obras destacadas …
-

Mercado
SetHvac transforma projeto de split em água gelada com ganhos para o cliente
Projeto original seria por um sistema de split com condensação a água, instaladora soube mostrar ao cliente …
-

Mercado
Trox aposta em suas tecnologias para modernização de edificação
Utilizando difusão convencional, VAVs e vigas-frias, de acordo com a ocupação, além de seus chillers modulares, empresa …
-

Mercado
Marco cultural e arquitetônico do Rio de Janeiro renasce em projeto audacioso
Antigo Cine Roxy, exemplo da arquitetura art déco da antiga capital federal, é repaginado climatização eficiente e …
-

Mercado
Arquipeo destaca-se pela eficiência energética e qualidade do ambiente
Empreendimento que atende Grupo WPP possui certificações LeedGold e Fitwel A Vila Leopoldina, antiga região de concentração …
-

Mercado
Interação instaladora e projetista garante sucesso do retrofit em aeroporto
Modernização do maior aeroporto da região Norte resultou em alta eficiência energética e superior qualidade do ar …
-

Eventos
Entrac visita Porto Alegre mais uma vez
Sempre receptivos, profissionais de todo o estado prestigiaram o tradicional evento itinerante do AVAC-R O Hotel Deville …
-

Mercado
Star Center entrega instalação energeticamente eficiente e com qualidade do ar
Equipamentos quente e frio simultaneamente elevam a eficiência da instalação; sistemas dedicados fazem o tratamento do ar …
-

Eventos
Edição 2025 do principal evento do AVAC-R fecha com números recordes
Crescimento em relação a 2023 foi de 40%, em número de marcas presentes o avanço foi de …
-

Qualidade do Ambiente Interno
Abrava integra Comissão Global da ONU para estabelecer marco regulatório e planos de ação
Em um movimento estratégico para posicionar a Qualidade do Ar Interno (QAI) como prioridade global de saúde …
-

1 Destaques
Febrava 2025 cresce 40% em público e consolida liderança
Evento recebeu mais de 35 mil visitantes e 600 marcas expositoras, batendo recorde de produtos e soluções …
-
Eventos
Marcas apostam em influenciadores e personalidades para movimentar mercado AVACR durante a Febrava 2025
Cafu, Nelson Piquet Jr, Fred Bruno e Formiga são algumas das personalidades que marcam presença na maior …
-

Mercado
Cinco motivos para visitar a Febrava 2025
Reconhecida como o maior e mais completo encontro do setor AVACR (Aquecimento, Ventilação, Ar-Condicionado e Refrigeração) da …
-
Mercado
Soler Palau Brasil Ventilação tem recomendação para a Certificação ISO 14001
A S&P Brasil Ventilação, subsidiária brasileira do grupo espanhol Soler & Palau, anuncia que foi recomendada para …
-

Eventos
Abrava reforça papel de porta-voz do setor na Febrava 2025
Entre os dias 8 e 12 de setembro, a Abrava marcará presença na Febrava 2025 com uma …
-

Projeto e Consultoria
ENPC mostra a evolução dos projetos nos últimos 25 anos e as tendências futuras
A edição comemorativa do 25º Encontro Nacional de Empresas Projetistas e Consultores da Abrava terá como tema …
-

Mercado
O que mostram alguns dos principais expositores da Febrava 2025
A Febrava 2025 cresceu em número de expositores e de marcas. Saiba em quais estandes conferir as …
-

Projeto e Consultoria
Conbrava: foco nos desafios climáticos e no futuro do setor AVACR
A 19ª edição do Conbrava, que abordará o tema O AVACR e os desafios das mudanças climáticas, …
-

Eventos
A Febrava, principal evento do AVACR do hemisfério sul, renova-se a cada edição
Em sua 23ª edição, a Febrava reúne mais de 600 marcas, amplia a área de exposições e …
-

Qualidade do Ambiente Interno
Ilhas temáticas e novos pavilhões marcam história da Febrava
Além do aumento da sua área de exposição em quase 20%, a Febrava 2025 contará com uma …
-

Eventos
Febrava 2025 mostra como o AVACR impulsiona o agronegócio
Tecnologias que reduzem perdas, aumentam a produtividade e fortalecem a competitividade do setor estarão em evidência de …
-

Cursos e Treinamentos
Febrava 2025 transforma feira em laboratório prático para profissionais do setor AVACR
Evento, que acontece de 9 a 12 de setembro no São Paulo Expo, terá ilhas temáticas com …
-

Manutenção e Operação
Os impactos do tratamento de águas: nova publicação da Abrava
O Departamento Nacional de Tratamento de Águas (DNTA), da Abrava, anuncia o lançamento do eBook “Os Impactos …
-

Eventos
Febrava: selo inovação aponta o futuro do AVACR
A Febrava acaba de anunciar os produtos e soluções reconhecidos pelo Selo Inovação deste ano, um dos …
-

Mercado
Febrava bate recordes e anuncia: marcas inéditas e retorno de gigantes do setor
Consolidada como a principal plataforma de inovação, negócios e tecnologia para o setor de AVAC-R (aquecimento, ventilação, …
-
Eventos
Desafios climáticos e o futuro do setor AVACR serão temas do Conbrava
Estão oficialmente abertas as inscrições para a 19ª edição do Conbrava (Congresso Brasileiro de Refrigeração, Ar Condicionado, …
-

Eventos
Principal feira do AVACR no hemisfério Sul anuncia novidades e a expansão para o Rio de Janeiro
Além do anúncio da edição carioca, promotora comemorou o aumento de 25% no espaço da feira que …
-

Cursos e Treinamentos
O mais longevo evento itinerante do AVACR visita o interior paulista
São José do Rio Preto, sede de uma das regiões administrativas mais prósperas do estado, foi palco …
-

Mercado
Evento da Midea compartilha estratégias para a liderança do setor
Com participantes de 18 países, evento da Midea apresentou portfólio de soluções, tendências de mercado e cases …
-

Qualidade do Ambiente Interno
3ª Edição do Seminário Nacional de Tratamento de Águas
No dia 17 de junho, o Comitê Nacional de Tratamento de Águas (CNTA) da Abravarealizou …
-
Eventos
Febrava 2025 abre credenciamento online e gratuito para visitantes
Está aberto o credenciamento online e gratuito para a 23ª edição da Febrava – Feira Internacional de …
-
Eventos
Febrava 2025 consolida liderança na América Latina
Entre os dias 9 e 12 de setembro, o São Paulo Expo sediará a 23ª edição da …
-

Gestão empresarial
Presença feminina no AVACR tem crescido significativamente
Crescimento demonstra que o setor evolui para um ambiente mais inclusivo e diversificado, com benefícios para a …
-

Cursos e Treinamentos
Principal evento itinerante do AVACR esteve em Natal
Mais de uma centena de profissionais acompanharam, com grande interesse, as palestras dos especialistas Após 8 anos, …
-

Eventos
Posse da nova diretoria da Abrava
No último 3 de junho, o engenheiro Leonardo Cozac assumiu a presidência da Abrava, tendo como vice-presidentes …
-
Qualidade do Ambiente Interno
Nova gestão do Qualindoor Abrava
Rafael Munhoz assume a presidência do Qualindoor ao lado do vice-presidente Frederico Paranhos para o biênio 2025–2026, …
-
Qualidade do Ambiente Interno
Qualidade do ar interno em eventos técnicos em Belo Horizonte
Dois importantes eventos sobre a qualidade do ar interno (QAI) aconteceram em Minas Gerais, nos dias 14 …
-

Projeto e Consultoria
Diretrizes da NBR 7256 para hospitais e estabelecimentos assistenciais de saúde
Norma, que passou por revisão, estabelece os requisitos mínimos para projetos de instalações de tratamento do ar …
-

Qualidade do Ambiente Interno
Novas estratégias de conforto, segurança e economia de energia em hospitais e estabelecimentos assistenciais de saúde
Na concepção de um projeto de AVAC hospitalar, primeiramente, é necessária a leitura da norma ABNT NBR …
-

Qualidade do Ambiente Interno
Sistemas de climatização em hospitais precisam ser estáveis e confiáveis
Sistemas de climatização em estabelecimentos assistenciais de saúde demandam não só a garantia de qualidade do ar …
-

Qualidade do Ambiente Interno
Tecnologias ativas são armas no combate à contaminação hospitalar
Além de seguir normas técnicas, são necessários estudos das áreas críticas e camadas extras de proteção As …
-

Projeto e Consultoria
Recomendações para o projeto de ar-condicionado hospitalar
A climatização de estabelecimentos assistenciais de saúde requer, além da observação de parâmetros de conforto e qualidade …
-

Qualidade do Ambiente Interno
NBR 16 401 começou a ser revisada em 2013
Dentre as novidades estão a introdução de dados climáticas de novas localidades e alteração no cálculo de …
-

Qualidade do Ambiente Interno
O que muda com a revisão da NBR 16 401
Norma brasileira da qualidade do ar interno é atualizada após quase duas décadas da sua criação e …
-

Qualidade do Ambiente Interno
Avanços na normatização da qualidade do ar interior
Após um período de, aproximadamente, 10 anos, a NBR 16 401 foi revisada e ampliada nas suas …
-

Eventos
A capital federal sedia o primeiro Entrac de 2025
Cerca de 150 profissionais compareceram ao evento que, neste ano, completa 25 anos de existência Mais uma …
-

Eficiência Energética
Um sistema distrital no coração do Recife Antigo
Central entregará água gelada ao conjunto de prédios multiuso, compreendendo lajes corporativas, salas de escritórios, lojas, restaurantes …
-

Mercado
BerlinerLuft comemora 25 anos de Brasil
Com o propósito de oferecer soluções inovadoras e de alta qualidade para sistemas de ventilação, climatização e …
-

Mercado
Tosi apresenta novas instalações
No último ano as Indústrias Tosi efetuaram um volume considerável de investimentos em novas instalações. Foram revitalizados …
-

Projeto e Consultoria
Os desafios de projetistas para a restauração e modernização de edifícios históricos
Projeto Neojiba em Salvador, Bahia O projetista e consultor Mário Sérgio de Almeida, diretor técnico da MSA …
-

Mercado
Inovação e qualificação e o crescimento regional foram pautas de evento em Fortaleza
No dia 12 de março, aconteceu, na sede do Crea em Fortaleza, o Panorama Setorial Abrava Nordeste, evento …
-

Cursos e Treinamentos
Aos 25 anos de vida, Sannar exibe vitalidade
Tradicional evento do AVACR recebeu mais de 350 profissionais com muito conteúdo técnico e novidades em produtos …
-

Eventos
Conferência destaca o tratamento de águas para AVACR em Brasília
No dia 25 de março, especialistas estiveram reunidos na V Conferência Nacional de Tratamento de Águas – …
-

Qualidade do Ambiente Interno
Ar-condicionado deve atender conforto térmico, custo do investimento e consumo
A climatização de estabelecimentos comerciais é essencial para garantir o conforto térmico de clientes e funcionários, …
-

Climatização
Para hiper e supermercados, o ideal são sistemas de água gelada
Mão não são descartadas soluções híbridas, considerando diferentes aplicações em umamesma instalação Em hipermercados, normalmente, falamos em …
-

Eficiência Energética
Supermercados reúnem condições ideais para a redução do uso de energia
Aplicação de sistemas energeticamente eficientes caracterizam-se pela adoção de altas temperaturas de resfriamento, baixas temperaturas de aquecimento, …
-

Mercado
Bry-Air comemora 60 anos de história
Grupo Pahwa é integrado por quatro empresas, todas voltadas às soluções de controle do ar ambiente Com …
-

Eventos
Um balanço da Conferência de Inverno da Ashrae
Número de participantes se mantém estável, mas publicação de papers cai Neste ano a Conferência de Inverno …
-

Eventos
Selo Inovação Febrava 2025
Estão abertas as inscrições para o selo inovação Febrava 2025, que visa destacar as soluções mais inovadoras no …
-

Projeto e Consultoria
Premiação inédita de engenharia de ar-condicionado para o Brasil
No dia 8 de fevereiro realizou-se a sessão plenária e encontro dos membros da Associação na Conferência …
-

Manutenção e Operação
O comissionamento durante o uso e manutenção de edificações
A compreensão equivocada sobre o processo nem sempre ocorre apenas no lado do contratante, observa-se no mercado …
-

Qualidade do Ambiente Interno
Norma 7256 – Uma visão sistêmica
Considerações relevantes sobre o artigo editado na Revista Abrava + Climatização& Refrigeração, n° 126 de setembro de …
-

Projeto e Consultoria
Complexo Porto Novo Recife avança no projeto de revitalização da antiga área portuária
Sistema distrital de produção de energia térmica alimenta instalações do hotel e do centro de convenções O …
-

Mercado
Perspectivas econômicas e oportunidades para 2025 para os setores da climatização e refrigeração
Cenário econômico, COP 30, Qualidade do Ar Interno, benefícios associativos, jurídicos e institucionais estão na pauta deste …
-

Manutenção e Operação
Workshop de tratamento de águas no setor de climatização e refrigeração
No dia 12 de dezembro, foi realizado o “Workshop de Tratamento de Águas para o setor AVACR”, …
-

Qualidade do Ambiente Interno
Selecionamento de filtros de ar para ventilação geral por cálculos de engenharia
A norma ABNT NBR ISO 16890-1:2018 oferece ao projetista a possibilidade de selecionar filtros e calcular taxas …
-
Eventos
Encontro de empresas projetistas e consultores da Abrava
O XXIV Encontro Nacional de Empresas Projetistas e Consultores (ENPC), promovido pelo Departamento Nacional de Empresas Projetistas e …
-
Qualidade do Ambiente Interno
Ashrae lança nova orientação para mitigar o impacto da fumaça na qualidade do ar interior
A Guideline 44-2024 oferece estratégias para manter ambientes internos mais saudáveis durante incêndios florestais e queimadas prescritas …
-

Manutenção e Operação
Educação do usuário é fundamental
O mito de que o ar-condicionado “faz mal” deve estar relacionado, na maior parte dos casos, a …
-

Projeto e Consultoria
Hospital mais antigo da Bahia monta centro de tratamento de medula óssea
Instalação segue as mais rigorosas práticas para a proteção dos pacientes O Hospital Santa Izabel deriva de …
-

Qualidade do Ambiente Interno
Como manter um ambiente saudável e confortável
Cada um tem uma história ou uma percepção de usuário sobre a questão de o ar-condicionado fazer …
-

Eficiência Energética
Entidade celebra 35 anos com homenagens e premiações
Ex-presidentes foram homenageados em comemoração aos 35 anos de existência;evento contou com a participação de Ceo da …
-

Qualidade do Ambiente Interno
Como o ar-condicionado pode contribuir para ambientes mais saudáveis
Instalações com falhas no projeto e instalação e, principalmente, operadas e mantidas fora das boas práticas, geram …
-

Cursos e Treinamentos
Com mais de uma centena de participantes, Entrac de Florianópolis mostra a força da região Sul
Realizado no Hotel Majestic evento tradicional do AVAC-R contou com 15 palestras técnicas Nos dias 25 e …
-

Eventos
MecaExpo discute eficiência e tendências de sustentabilidade
A MecaExpo é a primeira feira organizada pelo Grupo Mecalor com o objetivo de introduzir um novo …
-

Eficiência Energética
Best Clima traz tecnologia e conforto para o centro de negócios paulistano
Instaladora venceu na categoria obra nova – expansão direta O Parque é um empreendimento localizado no Brooklin, …
-

Automação
Sete obras são contempladas no 30º. Destaques do Ano Smacna Brasil
Ao completar 30 anos de existência, o Prêmio Destaques do Ano Smacna Brasil contabiliza, com as obras …
-

Climatização
Na Arena MRV, JAM executa obra com eficiência, qualidade do ar e baixo ruído
Dada as características da instalação, a melhor opção foi o sistema VRF, complementado por splits e splitões …
-

Climatização
OPJ vence obstáculos e entrega sistema eficiente de tratamento do ar
Considerando que o empreendimento não dispunha de espaços técnicos específicos para uma solução que não pudesse ser …
-

Climatização
Star Center moderniza edificação multiuso sem interromper as atividades
A escolha dos sistemas foi orientada pela diversidade de ocupação do Brazilian Financial Center (BFC), que abriga …
-

Eventos
Mais uma edição vitoriosa do Smacna Day
A Smacna Brasil (The Sheet Metal and Air Conditioning Contractors’ National Association), realizou a segunda edição do …
-

Conteúdo Patrocinado
Projeto de edificação recebe prêmio em eficiência energética
Instalação em uma unidade da rede de Saúde Mater Dei em Betim, Minas Gerais, Brasil Solução proposta: …
-

Projeto e Consultoria
Como interpretamos a Norma NBR 7256 para estabelecimentos assistenciais de saúde e por que usamos as normas técnicas – Parte I
Como interpretamos a Norma NBR 7256 para estabelecimentos assistenciais de saúde e por que usamos as normas …
-

Cursos e Treinamentos
Entrac de Vitória mobilizou mais de uma centena de profissionais
Evento itinerante já visitou, neste ano, Campo Grande e Uberlândia Vitória, no Espírito Santo, foi a anfitriã …
-

Eventos
Comitiva internacional para o Icarhma 2024
Entre os dias 21 e 23 de agosto, a Abrava e o Sindratar SP receberam a comitiva …
-
Qualidade do Ambiente Interno
Alterações na legislação sobre qualidade do ar interno
A Resolução 09 da Agência Nacional de Vigilância Sanitária (Anvisa), que estabelecia os padrões referenciais de qualidade …
-

Qualidade do Ambiente Interno
Qualidade do ar interno: padrão referencial passa a ser a Norma NBR 17.037/23
Com a revogação pela Anvisa da Resolução 09, o padrão referencial passa a ser a nova Norma …
-
Qualidade do Ambiente Interno
Monitoramento da qualidade do ar nas escolas de Canoas
A Asbrav – Associação Sul Brasileira de Refrigeração, Ar Condicionado, Aquecimento e Ventilação, em parceria com o …
-
Eventos
Mercofrio 2024
A preocupação com a Qualidade do Ar é uma das temáticas que estará presente no Mercofrio 2024, …
-

Manutenção e Operação
Gestão da manutenção: Trabalhando com os indicadores de performance
Todo o processo envolvendo o planejamento e a programação das atividades de manutenção em sistemas ou instalações …
-
Qualidade do Ambiente Interno
Alterações na legislação brasileira sobre qualidade do ar interno
A Abrava – Associação Brasileira de Refrigeração, Ar Condicionado, Ventilação e Aquecimento, por meio do seu Departamento …
-

Eventos
Seminário nacional de tratamento de águas e qualidade do ar interno
No dia 17 de julho aconteceu a 2ª Edição do Seminário Nacional de Tratamento de Águas e …
-

Qualidade do Ambiente Interno
Taxas de umidade relativa fora dos padrões estabelecidos causam prejuízos
Processos produtivos podem ser seriamente afetados pelo descontrole da umidade, debilitando a qualidade dos produtos ou, até …
-

Eventos
Em visita a Uberlândia, Entrac reúne mais de uma centena de profissionais
Evento itinerante cumpriu sua segunda etapa do ano com grande sucesso Mais de uma centena de profissionais …
-

Manutenção e Operação
Efeitos da umidade e tecnologias de controle
Além do desconforto térmico, taxas de umidades fora dos padrões aceitáveis contribuem para a proliferação de vírus …
-

Qualidade do Ambiente Interno
Como controlar a umidade em ambientes internos
Os autores decifram os efeitos da umidade descontrolada sobre a saúde dos ocupantes de ambientes climatizados e …
-

Ventilação e Exaustão
Medição, exibição e monitoramento contribuem para a manutenção da QAI
Os edifícios são responsáveis por 40% da demanda global de energia e das emissões de gases de …
-

Qualidade do Ambiente Interno
Controle de mofo após enchentes: Lições da catástrofe de maio de 2024 em Porto Alegre
A cidade de Porto Alegre, Rio Grande do Sul, viveu uma das piores catástrofes climáticas de sua …
-

Cursos e Treinamentos
Temporada de Entracs 2024 é inaugurada em Campo Grande
Cerca de uma centena de profissionais acompanharam as 14 palestras técnicas apresentadas Em sua primeira edição do …
-

Qualidade do Ambiente Interno
13ª QAI aborda os desafios em ambientes climatizados
Evento contou com palestras de profissionais dos principais laboratórios de produção de vacinas no país, além de …
-

Mercado
Painel Abrava na Hospitalar 2024
Estabelecimentos assistenciais de saúde precisam ter ambientes saudáveis? Essa foi a tônica do Painel Abrava na Hospitalar, …
-

Qualidade do Ambiente Interno
Empresas conscientes têm aumentado as ações para mitigação de riscos
Na pandemia, as tecnologias ativas se mostraram muito eficazes na inativação de patógenos sem causar aumentos do …
-

Qualidade do Ambiente Interno
Especificação de equipamentos requer a determinação de pré-requisitos a serem atendidos
Primeiramente, é necessário o respeito às determinações do projeto, às normas vigentes e às necessidades da instalação; …
-

Qualidade do Ambiente Interno
Um bom projeto de distribuição do ar contribui para a qualidade do ar
Um projeto de distribuição de ar bem elaborado, contribui para a qualidade do ar na medida em …
-

Projeto e Consultoria
Distribuição do ar é essencial na obtenção da qualidade e conforto
A forma mais eficaz de obter a melhor contribuição é favorecer a inalação antes da mistura com …
-

Qualidade do Ambiente Interno
Para cada tipo de aplicação, um sistema de difusão
Os sistemas de distribuição e difusão do ar prestam-se a proporcionar o máximo do conforto térmico e …
-

Gestão empresarial
Como um programa de ESG impacta no projeto de refrigeração e ar-condicionado
Embora o aspecto ambiental seja o que mais impacta o setor AVACR, um bom projeto também precisa …
-
Comissionamento e TAB
9º Workshop de Comissionamento
No último dia 30 de abril, aconteceu o 9º Workshop de Comissionamento de Edificações, realizado pelo Departamento …
-

Eventos
XXIV Sannar leva conteúdo técnico e novos produtos para Salvador
Realizado nos dias 3 e 4 de abril, tradicional evento do AVACR mais uma vez conseguiu atrair …
-
Qualidade do Ambiente Interno
ArmaComfort Laje: garantia de isolamento acústico
O conforto acústico é cada vez mais fundamental nos ambientes residenciais e profissionais. Pesquisa realizada pela ProAcústica …
-

Climatização
VRF x Água Gelada: Concorrentes ou complementares?
Inquestionavelmente, o VRF tem crescido bem mais do que os sistemas de água gelada. No entanto, não …
-

Manutenção e Operação
A importância do controle dos tempos dentro da atividade de manutenção
Para esclarecer a questão envolvendo a importância da medição ou apuração de tempos dentro das atividades de …
-

Mercado
Multivac comemora 35 anos de investimento contínuo em produtos e tecnologias
Combinando uma política comercial ousada com prudência nos investimentos, empresa conquistou a liderança em vários segmentos Na …
-

Eventos
Tendências para o AVAC em 2024
A AHR Expo é umevento global da indústria de AVAC, promovida pela Ashrae e AHRI desde 1930e …
-
Eventos
IV Conatrat discute tratamento de águas no AVACR em Porto Alegre
Aconteceu, no dia 21 de março, a IV Conferência Nacional de Tratamento de Águas (Conatrat), evento organizado …
-

Automação
Monitorar instalações de AVACR é prevenir falhas e atingir altos índices de eficiência
A maioria das empresas que atua no mercado de equipamentos para AVACR oferece pacotes de serviços que …
-
Manutenção e Operação
Lançamento da recomendação técnica sobre manejo de filtros de ar em sistemas de climatização
O Comitê Brasileiro de Refrigeração, Ar Condicionado, Ventilação e Aquecimento (CB-55) da Associação Brasileira de Normas Técnicas …
-

Cursos e Treinamentos
Abrava e FEI discutem capacitação e qualificação de profissionais para o setor AVACR
Situação preocupante, a falta de engenheiros especializados nos quatro setores do AVACR representados pela Abrava foi o …
-

Automação
Monitoramento remoto é aplicável em qualquer instalação com acesso à internet
A revista Abrava + Climatização & Refrigeração (A+CR) conversou, via email, com 3 profissionais da Trox do …
-

Automação
Obtenção de informações analíticas facilita a tomada de decisões
Quando monitoramos remotamente o sistema de AVACR, é possível obter eficiência enérgica, sustentabilidade, confiabilidade, segurança, melhorias operacionais, …
-

Automação
Monitoramento remoto é bastante acessível
O monitoramento remoto do sistema AVAC permite acompanhar em tempo real os parâmetros, performance, eficiência e eventuais …
-

Climatização
Ar-condicionado em residências: aspectos energéticos e qualidade do ar interior
As ondas de calor têm promovido o aumento da demanda por sistemas de climatização nas residências no …
-

Projeto e Consultoria
Dicas de exaustão de cozinhas e ventilação para cozinhas profissionais: Pontos de atenção nos projetos
Temperaturas internas, umidade, ruido e cheiro são pontos de atenção para a brigada, para os clientes e …
-

Mercado
Faturamento do AVAC-R deve chegar a R$ 41 bilhões em 2024
A 5ª edição do “Abrava de Portas Abertas”, tradicional evento de apresentação da Associação para o mercado, …
-

Automação
Estabelecimentos comerciais de pequeno porte já podem se beneficiar dos avanços tecnológicos
Da mesma maneira, qual o alcance e as limitações para o desenvolvimento de sistemas de automação baseados …
-

Gestão empresarial
Prêmio “Destaques do Ano” traz mudança de patamar para a vencedora e para o mercado
Principal premiação do mercado de AVAC, com 30 anos de existênciacompletados no ano passado, não possui barreiras, …
-

Eventos
O principal encontro do AVAC-R do Norte-Nordeste já tem data marcada
O Salão Norte-Nordeste de Ar-Condicionado e Refrigeração do Norte-Nordeste (Sannar), principal encontro do AVAC-R da região, acontecerá …
-

Eventos
Confirmada a realização do Mercofrio 2024
O Congresso Mercofrio 2024, organizado pelo Associação Sul Brasileira de Refrigeração, Ar Condicionado, Aquecimento e Ventilação (Asbrav), …
-

Projeto e Consultoria
Tradicional premiação da Smacna Brasil destaca 6 instalações
Cerimônia de premiação aconteceu em novembro e contou com a participação dos mais variados agentes do mercado …
-

Qualidade do Ambiente Interno
Eficiência energética e qualidade do ar impulsionam soluções
A busca pela eficiência energética e descarbonização no setor de AVAC-R tem implicação direta nas tecnologias e …
-

Qualidade do Ambiente Interno
Tecnologia de filtragem líquida
A busca pela inovação tecnológica se aguça diante dos desafios, como o atual aquecimento global conjugado com …
-

Qualidade do Ambiente Interno
Ashrae 241 estabelece requisitos para redução do risco de contaminação por aerossóis
Com a elevação da preocupação com ambientes mais saudáveis, cresce a tendência de edificações AAA buscarem certificados …
-

Vídeos
PMOC pós-pandemia: uma pesquisa com gestores de instalações
O Professor João Pimenta, com uma equipe de alunos da sua disciplina na Escola de En genharia …
-

Vídeos
Comissionamento de projeto
Tomaz Cleto e Mauricio Salomão Rodrigues falam sobre a atividade de comissionamento no Brasil e mostram a …
-

Climatização
Nutera-RP: Climatização eficiente para um avançado centro de combate ao câncer
O novo Núcleo de Terapia Celular Avançada de Ribeirão Preto (Nutera-RP) integra o maior programa de tratamento …
-

Climatização
Catedral de Cascavel: conforto térmico com respeito às características arquitetônicas
A Catedral Metropolitana de Cascavel – Nossa Senhora Aparecida, foi construída entre 1974 e 1976. Projeto assinado …
-

Manutenção e Operação
Como manter o ambiente do supermercado seguro e confortável para ocupantes?
Por se tratar de um ambiente de uso público e coletivo, o estabelecimento deve implementar e manter …
-

Manutenção e Operação
Planejamento da manutenção para a preservação de funções em sistemas de AVAC-R
Independentemente de planejamento, observa-se o equivocado direcionamento de atividades de manutenção apenas ao equipamento Ainda que a …
-

Climatização
Seis obras recebem o Prêmio Destaques do Ano Smacna Brasil
Instituído em 1994, o Prêmio Destaques do Ano Smacna Brasil contabiliza, com as obras destacadas na presente …
-

Projeto e Consultoria
UTI – Climatização em diversas configurações
Projetistas de ar-condicionado de estabelecimentos assistenciais de saúde são responsáveis por projetos de climatização desses ambientes, e …
-

Qualidade do Ambiente Interno
Luna Crescente: Modernização das instalações confere padrão triple A ao empreendimento
O complexo de escritórios Luna, situado na zona sul da cidade de São Paulo, consta de duas …
-

Climatização
São Luiz Osasco: Eficiência dos sistemas de AVAC e mitigação do desperdício de água
O Hospital e Maternidade São Luiz Osasco oferece uma ampla gama de serviços médicos, incluindo atendimento multidisciplinar, …
-

Eficiência Energética
Mater Dei Salvador: climatização por vigas frias e alta qualidade do ar interno
Ganhos energéticos e na qualidade do ar são comprovadamente superiores aos sistemas todo ar, com um custo …
-

Eventos
Febrava: especial em todos os sentidos
Em seu retorno ao formato 100% presencial, o principal encontro sul-americano do AVAC-R esbanjou novidades Igualmente abundante …
-

Climatização
Midea lança o V8, para residências de alto padrão e segmento comercial
No dia 14 de setembro, durante a realização da 22ª. Febrava, a Midea apresentou o novo modelo …
-

Cursos e Treinamentos
Congresso técnico-científico aponta tendências para o AVAC-R
AVAC-R rumo a um futuro sustentável e saudável foi o tema do XVIII Conbrava O Congresso Brasileiro de …
-

Projeto e Consultoria
Climatização e refrigeração: Conforto ou necessidade?
Encontro de projetistas e consultores debate a gênese dos sistemas de ar-condicionado e refrigeração Mais de 200 …
-

Eventos
Primeira edição do Prêmio Nelson Baptista
Premiação homenageia profissional que alavancou, por anos, a Febrava A premiação da 1ª edição do “Prêmio Nelson Baptista”, …
-

Qualidade do Ambiente Interno
Definindo o conforto térmico
A partir de uma sugestão no Conselho Editorial da revista Abrava+Climatização & Refrigeração, no sentido de recuperar …
-

Qualidade do Ambiente Interno
A negligência quanto ao controle de umidade, infelizmente, não é rara
Talvez isso se dê devido ao nosso clima, em geral pouco desafiador No meu entendimento, os requisitos …
-

Qualidade do Ambiente Interno
Nossos objetivos são fornecer conforto térmico e qualidade do ar
Por mais sofisticados os sistemas que projetamos, fornecemos e instalamos, caso não cumpram os objetivos propostos evidentemente …
-
Qualidade do Ambiente Interno
Ecoquest cria unidade de negócios exclusiva para combate ao mofo
Sem tratamento, o mofo pode prejudicar a saúde dos ocupantes – provocando alergias, pneumonia, asma, infecções – …
-

Eventos
Selo Destaque Inovação Febrava 2023 premia a tecnologia
Iniciativa da Abrava e RX, o Selo Inovação Febrava 2023 escolheu mais de 70 produtos por suas …
-

Cursos e Treinamentos
Ribeirão Preto sedia evento para profissionais ligados ao AVACR
Após 5 anos, Entrac retorna a Ribeirão Preto sendo recebido com entusiasmo pelos profissionais da região Ribeirão …
-

Climatização
Um novo olhar sobre o conforto térmico
A sensação de bem-estar é ampliada quando a qualidade de ar dos ambientes está em conformidade Quando …
-

Qualidade do Ambiente Interno
Os desafios para o controle de umidade
Este artigo tem como objetivo apresentar um panorama do controle de umidade e os principais desafios relacionados …
-

Eventos
Após 4 anos, expositores depositam fortes expectativas na Febrava
A opinião é unânime: esta edição da maior feira do AVAC-R na América Latina tem tudo para …
-

Projeto e Consultoria
Soluções técnicas de menor investimento para aplicação da ABNT NBR 7256
A norma brasileira ABNT NBR 7256, Tratamento de ar em estabelecimentos assistenciais de saúde (EAS) – Requisitos …
-

Eventos
Público com maior poder de decisão é esperado no grande evento do AVACR
Além da exposição, Febrava reserva inúmeras atrações a que visita-la; destaque para os eventos simultâneos e ilhas …
-

Cursos e Treinamentos
Principal encontro técnico-científico do AVACR debate um futuro sustentável e saudável
Sob tema “AVACR rumo a um futuro sustentável e saudável”, o XVIII Conbrava acontece entre os dias …
-

Climatização
Assembleia Anual da Faiar aconteceu no México
A edição da Assembleia Faiar 2023 aconteceu entre os dias 12 e 16 de julho e reuniu …
-

Qualidade do Ambiente Interno
Trox apresenta case de sucesso no uso de vigas frias em hospitais
No dia 22 de junho último, no Hotel Tivoli Mofarrej, foi realizado o Trox Fórum Healthcare – …
-

Gestão empresarial
Sicflux inaugura showroom
A Sicflux, que já possui um showroom completo na sua fábrica em Araquari-SC, acaba de inaugurar um …
-

Eficiência Energética
Mater Dei Salvador adota climatização por vigas frias
Ganhos energéticos e na qualidade do ar são comprovadamente superiores aos sistemas todo ar, com um custo …
-

Cursos e Treinamentos
Após 7 anos Entrac retorna a Manaus
Manaus, capital do Amazonas, sediou a edição de junho do Encontro Tecnológico de Refrigeração e Ar-Condicionado (Entrac). …
-

4 Home
Tratamento de águas e qualidade do ar foram debatidos em Santa Catarina
Aconteceu no dia 20 de junho, a 1ª edição do Seminário de Qualidade do Ar e Tratamento …
-

Eventos
Febrava 2023 anuncia abertura do credenciamento
A Febrava (Feira Internacional do Setor de Refrigeração, Ar condicionado, Ventilação, Aquecimento, Tratamento do Ar e de …
-

Cursos e Treinamentos
Conbrava 2023 abre as inscrições
O XVIII Congresso Brasileiro de Refrigeração, Ar Condicionado, Ventilação, Aquecimento e Tratamento de Ar (Conbrava) que …
-

Qualidade do Ambiente Interno
Lançado convênio Conforlab-Fiocruz para a pesquisa em qualidade do ar interno
No último 19 de maio a Conforlab reuniu um grupo de profissionais envolvidos com a qualidade do …
-
Qualidade do Ambiente Interno
Nova norma de qualidade do ar interior
No último 25 de abril foi publicada a ABNT NBR 17037:2023 Qualidade do ar interior em ambientes …
-

Qualidade do Ambiente Interno
Arthur Aikawa quer ampliar a disseminação de informações sobre a importância da qai
No dia 9 de maio aconteceu a primeira reunião do Departamento Nacional de Qualidade do Ar Interno …
-

Qualidade do Ambiente Interno
Painel Abrava na Hospitalar 2023
A ABNT NBR 7256 – Tratamento de ar em estabelecimentos assistenciais de saúde (EAS) – Requisitos para …
-

Projeto e Consultoria
Mater Dei Betim-Contagem incorpora soluções eficientes
Projeto de ar-condicionado teve premiação da Ashrae pela eficiência energética com generosas taxas de renovação do ar …
-

Automação
O BMS e a busca pela eficiência energética
Longe de ser meramente custo, a tecnologia deve ser encarada como um investimento acessível a todos os …
-

Qualidade do Ambiente Interno
Com o esmorecimento da pandemia a preocupação com a QAI sobrevive?
Os cuidados com a qualidade do ar interno, marcantes no início dos casos de Covid-19, talvez não …
-

Cursos e Treinamentos
Mais um Entrac vitorioso na Cidade Maravilhosa
O Windsor Florida Hotel, no Flamengo, sediou, nos dias 10 e 11 de maio, o Encontro Tecnológico …
-

Projeto e Consultoria
Sucesso da Norma depende de projetistas, fornecedores, instaladores e contratantes
Cada agente pode contribuir para otimizar a execução o custo total e considerar que a melhoria tem …
-

Projeto e Consultoria
Aplicação da última edição da NBR 7256 amplia adesão e estimula mercado
A aplicação da última revisão da Norma ganha a adesão de projetistas e contratantes e provoca o …
-

Qualidade do Ambiente Interno
Qualidade do ar interno ganha livro
O Qualindoor Abrava (Departamento Nacional da Qualidade do Ar Interno da Abrava) apresenta a primeira publicação com …
-

Manutenção e Operação
Tratamento de águas no AVAC-R – importância, referências e mitos
Estou em tratamento de águas há 38 anos, acompanhei várias atualizações, o surgimento de tecnologias sustentáveis e …
-

Cursos e Treinamentos
Encontro tecnológico de refrigeração e ar-condicionado de Belo Horizonte
Primeira edição do evento reuniu mais de uma centena de profissionais Dias 12 e 13 de abril …
-

Manutenção e Operação
Boas práticas em sistemas de ar-condicionado
O Ministério do Meio Ambiente e Mudança do Clima (MMA), no âmbito do Programa Brasileiro de Eliminação …
-

Automação
O papel das válvulas e controles na manutenção da qualidade do ar
As válvulas de controle são cruciais para a manutenção da QAI, já que ajudam a regular a …
-

Automação
Válvulas e controles jogam papel decisivo para a manutenção da QAI
IoT permite implantar lógicas para otimização dos sistemas através da análise dos dados em tempo real Todos …
-

Qualidade do Ambiente Interno
Debate sobre a qualidade do ar passa por amadurecimento
Segmento de ar-condicionado é o principal agente pela condução de um debate responsável A qualidade do ar …
-

Ventilação e Exaustão
O ideal é encontrar o ponto certo entre QAI e eficiência energética
Mesmo controlada a pandemia da Covid-19, os investimentos em qualidade do ar devem ser mantidos Uma “herança” …
-

Qualidade do Ambiente Interno
Algumas soluções ativas ganham espaço
A percepção, pós-pandemia, é que há um conhecimento maior sobre a importância da qualidade do ar em …
-

Qualidade do Ambiente Interno
A importância da qualidade do ar interno e a busca pelo direito de respirar um ar de qualidade
O 12º Seminário Internacional de Qualidade do Ar Interno, que abordou a qualidade do ar em estabelecimentos assistenciais …
-

Projeto e Consultoria
Já se percebem os impactos positivos da revisão da Norma
Além de linhas especiais de equipamentos, as novas diretrizes merecem atenção acurada de empresas projetistas É possível …
-

Qualidade do Ambiente Interno
É preciso conscientizar que nosso trabalho é fundamental
Jorge Zato, gerente corporativo de engenharia e P&D da Trox do Brasil, resume a nova NBR 7256 …
-

Eventos
Sannar 2023 foi realizado em Fortaleza
A capital cearense sediou a edição mais recente do evento que acontece há mais de duas décadas …
-

Projeto e Consultoria
Hospital dia tem desacoplamento total entre cargas para a eficiência e qualidade do ar
Embora trabalhando com limitações de espaço e tempo, projeto calcado em mini chillers consegue entregar economia de …
-

Qualidade do Ambiente Interno
Qualidade do ar em dois eventos: Expoqualindoor e Encontro Nacional de Fiscalização
Infelizmente é sabido que muitos ambientes de grande circulação como hospitais, shopping, cinemas, escolas, faculdades, academias, supermercados, …
-

Gestão empresarial
Há muito a ser feito para corrigir os efeitos dos riscos ambientais e da desigualdade
ESG são ações corporativas capazes de evitar, mitigar ou compensar a degradação ambiental e promover o bem-estar …
-

Meio Ambiente
Setor AVAC-R pauta a adoção de padrões e práticas ESG
Embora sustentado por alguns projetistas e consultores, e grande parte da indústria, adoção do conceito esbarra na …
-

Qualidade do Ambiente Interno
Análise comparativa entre sistemas DOAS com vigas frias e convencional por meio de simulação
A utilização de água para o transporte de calor favorece ganhos energéticos em relação ao uso do …
-

Gestão empresarial
Caminho sem volta
Interpreto a questão da ESG como uma rota de transformação empresarial e social que contempla três pilares: …
-

Eficiência Energética
O principal motor da agenda ESG é o combate às mudanças climáticas
O debate em torno às demandas e conceito do ESG recém-começaram no setor de climatização e refrigeração …
-

Energia e Meio Ambiente
Devemos apoiar e incentivar as boas práticas nas companhias
A questão ESG está na moda atraindo muitas empresas privadas, o setor público, e organizações não governamentais …
-

Gestão empresarial
Apurada visão holística das cadeias de valor
ESG é uma demanda oriunda do setor financeiro nascida em 2006, impulsionada pela ONU, e fundamentada nos …
-

Ventilação e Exaustão
Resfriamento evaporativo para conforto térmico e saúde ocupacional
Tecnologia pode climatizar ambientes industriais acrescentando conforto e produtividade aos colaboradores e adequando a empresa às diversas …
-

Manutenção e Operação
Ferramentas incentivam integração entre fabricantes e prestadores de serviços
O sistema de automação com comunicação IoT tem papel fundamental na nova tendência de integração e …
-

Projeto e Consultoria
Requisitos de projeto, bons produtos e comissionamento são fundamentais
IoT, machine learning e cloud computing são tecnologias que têm trazido eficiência aos sistemas, com predição …
-

Qualidade do Ambiente Interno
Novas ferramentas garantem qualidade dos ambientes e produtos com economia de energia
Ferramentas e tecnologias, como internet das coisas, inteligência artificial e computação em nuvem, são cada vez mais …
-

Automação
Eficiência em processos e redução de custos justificam investimento em tecnologia
Os sistemas atuais comportam um número altíssimo de variáveis além de grande complexidade para atendimento das …
-

Climatização
Apesar da maior complexidade, as soluções entregam gestão simplificada e inteligente
A operação e manutenção de sistemas de climatização têm gradativamente se apoiado em novas tecnologias para …
-

Manutenção e Operação
AVAC-R adapta-se rapidamente às inovações
Rotinas de manutenção preventiva podem ser programadas com base nos parâmetros operacionais, como troca dos filtros próximos …
-

Eficiência Energética
2ª edição do Livro Acordo Ambiental São Paulo
No dia 14 de dezembro, a Abrava esteve presente na Cetesb (Companhia Ambiental do Estado de São …
-

Manutenção e Operação
Manutenções complexas exigem a participação de técnicos treinados
A necessidade de manutenção da qualidade do ar interno não é restrita a grandes instalações. Em ambientes …
-

Manutenção e Operação
Os procedimentos de higienização são fundamentais para preservar a saúde dos usuários
Para que o equipamento da linha split funcione nas suas melhores condições, além da instalação que deve seguir …
-

Eficiência Energética
Monitoramento permite controlar a qualidade do ar interno e o consumo energético
Para que os benefícios sejam amplos, os parâmetros devem ser estabelecidos com envolvimento de especialistas em AVAC-R …
-

Automação
Monitoramento em tempo real garante a qualidade dos ambientes internos e menor consumo de energia
Especialistas da indústria do AVAC-R fazem suas recomendações para que os sistemas trabalhem sempre em seu ponto …
-
Climatização
Tendências do ano de 2022 para o Setor de AVAC-R e o que esperar para 2023
Estamos chegando ao final de 2022 e, como sempre, repensar o ano que está para se encerrar …
-

Climatização
Principal entidade do setor AVAC-R na América Latina está em renovação permanente
Associação acompanhou e alicerçou a evolução do setor AVAC-R, dando respostas às necessidades do mercado e da …
-

Gestão empresarial
Trox Road Show encerra sua turnê de 2022
Com passagens pelas cidades de Belo Horizonte e Porto Alegre, a agenda de Road Show de 2022 …
-

Gestão empresarial
Evento de premiação das obras do ano tem público recorde
Oito instalações foram laureadas com o Prêmio Destaques do Ano 2022 da Smacna Em 20 de novembro …
-

Eventos
10ª Semana Tecnológica Senai-Abrava de Refrigeração e Climatização aborda novas tecnologias, meio ambiente e boas práticas
Mais de 40 palestras e público superior a 2.000 pessoas participaram da “10ª Semana Tecnológica de Refrigeração e …
-

Qualidade do Ambiente Interno
VII ExpoQualindoor debate qualidade do ar e seu efeito na produtividade e bem-estar
A VII ExpoQualindoor, realizada no último 26 de outubro, tratou do tema Como impactar a produtividade e o …
-

Cursos e Treinamentos
Entrac fecha a programação de 2022 em Belém do Pará
A última edição do ano dos Entracs (Encontros Tecnológicos de Refrigeração e Ar-Condicionado) aconteceu nos dias 19 …
-
Eventos
Conbrava 2023 abre chamada de trabalhos
Entre os dias 13 e 15 de setembro de 2023, acontecerá o XVIII Conbrava – Congresso Brasileiro …
-
Qualidade do Ambiente Interno
Abrava coloca em debate QAI, eficiência energética e treinamento e capacitação de profissionais na Icarhma 2022
Setor considerado essencial durante a pandemia de Covid-19 e cada vez mais importante para toda sociedade, o …
-
Comissionamento e TAB
7 º Workshop de Comissionamento
Realizado em duas etapas, no mês de outubro aconteceu em Minas Gerais a segunda edição do 7 …
-

Conteúdo Patrocinado
LG antecipa nova classificação A do Inmetro e lança novos produtos
Além de se adiantar para oferecer ao mercado produtos com alta eficiência energética, empresa lança linha UV, …
-

Projeto e Consultoria
Encontro de projetistas debaterá qualidade do ar e eficiência energética
Dias 17 e 18 de novembro Curitiba sediará o XXI Encontro Nacional de Empresas Projetistas e Consultores, …
-

Eficiência Energética
LG antecipa nova classificação A do Inmetro e lança novos produtos
Os critérios de avaliação de eficiência energética de equipamentos de ar-condicionado, com o objetivo de elevar os …
-

Qualidade do Ambiente Interno
Retrofit na CAG do Hospital Badim 1
Dificuldade de execução e velocidade de execução, foram diferenciais para a escolha da obra O Hospital Badim, …
-

Eficiência Energética
Sintonia entre instaladora, projetista e construtora garantiram o sucesso
Centro de Ensino e Pesquisa Albert Einstein tem projeto do icônico Moshe Safdie O novo Centro de …
-

Qualidade do Ambiente Interno
No Castelo Mourisco o desafio foi controlar temperatura e umidade do ar externo
Soluções propostas foram baseadas em estudos e pesquisas dedicadas a soluções de climatização em museus Os sistemas …
-
Eficiência Energética
Especialistas debatem evoluções e novos requisitos
A Abrava, por meio do Departamento Nacional de Fabricantes de Ar-Condicionado, promoveu no dia 22 de setembro …
-

Processos Industriais
Água gelada e água quente em um grande complexo aquático
Perfil de cargas térmicas e necessidade de controle rigoroso de temperatura e umidade são diferenciais no Acquamotion …
-

Qualidade do Ambiente Interno
Laboratório de difusão de ar
No último 5 de outubro a Trox Brasil inaugurou o seu laboratório de difusão do ar na …
-

Qualidade do Ambiente Interno
VII Expoqualindoor em Campinas no dia 26 de outubro
No dia 26 de outubro, acontecerá a VII EXPOQUALINDOOR com o tema “Como Impactar a produtividade e …
-

Gestão empresarial
Purificador com renovação de ar
A Purefeel anuncia a obtenção da patente do seu purificador de ar. O pedido, protocolado há menos …
-

Cursos e Treinamentos
10ª Semana Tecnológica Senai-Abrava de Refrigeração e Climatização
Mais de 40 palestras e público superior a 2.000 pessoas marcaram a “10ª Semana Tecnológica de Refrigeração …
-

Cursos e Treinamentos
Smacna Brasil promove encontro com foco no cliente final
A Smacna Brasil (Sheet Metal and Air Conditioning Contractors’ National Association), realizou o Smacna Day, no último …
-
Qualidade do Ambiente Interno
Plano de gestão da qualidade de área interna é assunto de painel
O maior encontro de negócios do setor de Facility Management brasileiro, que teve início no dia 9, no …
-

Eventos
Pela primeira vez em 22 anos, Entrac acontece em São Paulo
Dias 17 e 18 de agosto foi a vez de São Paulo sediar um Entrac – Encontro …
-

Projeto e Consultoria
BIM e simulação computacional em sistemas de AVAC
O desenvolvimento de projetos de engenharia e arquitetura tem migrado cada vez mais do 2D para o …
-

Climatização
Por que os sistemas perdem as condições de projeto?
Como qualquer sistema ou equipamento mecânico, o ar-condicionado pode, com o tempo, apresentar queda no desempenho de …
-

Manutenção e Operação
Manutenção inadequada e operação deficiente provocam mau desempenho dos sistemas
Um sistema de água gelada com um bom desempenho cumprirá seu objetivo final de forma eficiente e …
-
Automação
Sistemas de medição da qualidade do ar contribuem para a saúde da população
Antes voltados ao conforto térmico do consumidor em ambientes fechados, como shoppings, teatros e escritórios, os sistemas …
-

Cursos e Treinamentos
Porto Alegre recebe road show da Trox
Após Belo Horizonte, no mês de junho, Porto Alegre foi a outra cidade a receber, no dia …
-
Eventos
Inscrições para o Congresso Mercofrio
O Congresso Mercofrio, que acontecerá entre 13 e 15 de setembro reunindo especialistas em diversas áreas, já …
-

Comissionamento e TAB
Análise de desempenho e retrocomissionamento de sistemas
Para que o processo tenha sucesso é necessário que o Provedor do RCx tenha liberdade para envolver …
-

Gestão empresarial
Sicflux comemora 30 anos de vida com planos de expansão
Nascida em São Paulo, no bairro do Ipiranga, a empresa hoje ocupa modernas instalações industriais em Araquari, …
-

Gestão empresarial
Há 8 anos Abrava e Nova Técnica iniciavam o projeto da nova revista
Após 100 edições, projeto original mantém seus pressupostos básicos sem perder a renovação Em abril de 2014 …
-

Gestão empresarial
Uma unificação bem-sucedida
“Tadeu Neaime era o Presidente da Abrava e eu o Vice-presidente. Nós tínhamos a mesma interpretação em …
-

Cursos e Treinamentos
Goiânia e Anápolis sediaram mais uma rodada de Entracs
Cerca de 120 profissionais prestigiaram o evento em Goiânia Prosseguindo na programação 2022 do Encontro Tecnológico de …
-

Processos Industriais
Tratamento do ar em instalações especiais
Os equipamentos para o tratamento do ar em instalações especiais, por operar de forma ininterrupta 24 horas …
-
Eventos
Mercofrio 2022 debaterá mudanças climáticas
O Congresso Mercofrio, importante ponto de encontro entre profissionais do AVAC-R brasileiro, será realizado de 13 a …
-
Gestão empresarial
Carrier lança novo modelo de VRF
A Carrier, lança um novo modelo da linha VRF, o XPower New Generation. Segundo a marca, o …
-

Manutenção e Operação
Água gelada X VRF: Operação e manutenção têm semelhanças
Ambos os sistemas podem atender às necessidades de renovação do ar; a manutenção dos VRF, devido a …
-

Climatização
Água gelada x VRF: delimitando o espaço de cada um dos sistemas
Numa definição esquemática pode-se considerar que os sistemas VRF estão destinados às instalações residenciais de alto padrão …
-

Cursos e Treinamentos
Em Curitiba, profissionais discutem qualidade do ar e eficiência energética
A edição 2022 do Entrac continuou com a visita a Curitiba, onde um público significativo acompanhou 14 …
-
Climatização
Recondução do Conselho de administração e diretoria da Abrava
Próxima de celebrar 60 anos de fundação, a ABRAVA deu posse nesta quinta-feira, 9 de junho, aos …
-

4 Home
Impermeabilização correta pode prevenir
A umidade, o mofo e o bolor constituem agentes nocivos à saúde humana. A falta de ventilação …
-

Projeto e Consultoria
NBR 7256: Como ficam os projetos em andamento e tendências para a adaptação dos novos projetos
Buscando trazer aos leitores a nova versão da NBR 7256 Tratamento de ar em estabelecimentos assistenciais de …
-

Projeto e Consultoria
Revisão e atualização dos parâmetros de projeto
Os vários ambientes dos Estabelecimentos Assistenciais de Saúde são especificados em sete tabelas constantes na Norma Um …
-

Projeto e Consultoria
Principais alterações: Ambientes classificados e descritos em função do seu risco ambiental
Wili Hoffmann esclarece algumas das principais adequações, assim como a inclusão dos diversos conceitos, equiparando a NBR …
-

Projeto e Consultoria
Seção 9 da nova ABNT NBR 7256 aborda a segurança nas EAS
Requisitos essenciais para majorar as condições de segurança contra incêndio são estipulados na Norma Tem-se verificado um …
-

Gestão empresarial
Proteção para os fiéis
Centros religiosos, como templos e igrejas, estão entre os locais com maior risco de transmissão do Sars-CoV-2. …
-

Projeto e Consultoria
Novas diretrizes da ABNT 7256:2021
Foi lançada em 2021 a nova versão da Norma Brasileira ABNT 7256, com revisão técnica e atualização …
-

Cursos e Treinamentos
Entrac abre a temporada 2022 em Cuiabá
Após 2 anos de restrições impostas pela pandemia da Covid-19, os ENTRACs (Encontros Tecnológicos de Refrigeração e …
-

Qualidade do Ambiente Interno
Qualidade do Ar Interno, novo paradigma em gestão de ambientes
A renovação do ar é uma das ações mais simples para melhorar a qualidade do ar interno. …
-

Qualidade do Ambiente Interno
Nível de umidade e o tempo de exposição podem causar danos irreparáveis
A qualidade do ar interior entrou definitivamente no rol das preocupações de gestores de edifícios climatizados, consequência …
-

Qualidade do Ambiente Interno
A umidade é heroína ou vilã em ambientes climatizados?
O controle da umidade, sob a ótica do conforto, na faixa de UR 45-55%@24°C+/-0,5°C, permanece pacificado como …
-

Qualidade do Ambiente Interno
Efetividade do controle da temperatura
As espécies de fungo (mofo) são muitas, mas não necessariamente demandam o mesmo nível de preocupação dos …
-

Qualidade do Ambiente Interno
Controle da umidade relativa é preocupação global
Com a pandemia as pessoas entenderam o grave risco que existe em um ambiente com umidade baixa …
-

Qualidade do Ambiente Interno
Umidade, contaminação microbiológica e efeitos na saúde
O estudo de ambientes internos tornou-se um campo da ciência nos últimos anos. As interações complexas entre …
-

Eficiência Energética
Como driblar os efeitos da crise energética?
Independente de crise ou de oportunidades, a eficiência energética nos sistemas de AVAC é um dos requisitos …
-

Qualidade do Ambiente Interno
Sistemas dedicados de tratamento do ar e recuperadores de calor
O papel do ar externo em ambientes climatizados está relacionado a alguns fatores, como: – Diluição de …
-

Climatização
Soluções eficientes para os lados da água e do ar
Podemos analisar os sistemas de água gelada por duas perspectivas. Do lado da água, o que se …
-

Eventos
22ª edição do Salão Norte-Nordeste de Ar-Condicionado e Refrigeração reúne público qualificado
Após dois anos de restrições impostas pela pandemia, o Salão Norte-Nordeste de Ar-Condicionado e Refrigeração (Sannar) pode, …
-

Qualidade do Ambiente Interno
Medidas para qualidade do ar, segurança e saúde em eventos
Evidências científicas comprovam a disseminação em massa da Covid-19 a partir de aglomerações sociais. Diversos são os …
-
Qualidade do Ambiente Interno
Midea Carrier doa equipamentos de purificação do ar
A Midea Carrier realizou a doação de sistemas de purificação de ar para 10 Unidades de Pronto …
-

Comissionamento e TAB
Fatores de atenção no projeto e instalação de dutos para sistemas de ar-condicionado
Os dutos são componentes centrais de sistemas de ar-condicionado. As condições de projeto, instalação, formato e materiais …
-

Qualidade do Ambiente Interno
As lições da pandemia aos profissionais do AVAC e gestores prediais
Embora de menor letalidade, a variante ômicron veio dar razão não somente àqueles que acreditam ser impossível …
-

Qualidade do Ambiente Interno
É necessário trazer as instalações para a operação segundo as especificações de projeto
Frente à pandemia da Covid-19, no que diz respeito aos sistemas de renovação do ar, alguns protocolos …
-

Eficiência Energética
Controle entálpico pode proporcionar até 100% de ar de renovação
A automação é um item que pode contribuir significativamente no aspecto de eficiência energética da instalação como …
-

Automação
Tecnologias ativas e automação
Hoje, diante do novo normal, as tecnologias ativas farão a diferença no cotidiano das pessoas e das …
-

Qualidade do Ambiente Interno
Consolida-se a preocupação com a saúde e bem-estar nos ambientes internos
A tecnologia ativa Active Pure de 5a geração, por exemplo, proporciona um grande aumento da biossegurança dos …
-

Qualidade do Ambiente Interno
Tecnologias ativas para purificação do ar ganham espaço
Embora um tema novo e, de certa forma, controverso, as tecnologias ativas para o tratamento do ar …
-

Manutenção e Operação
Recomendações de filtragem para os diversos tipos de ambientes
Vitor Serigatti, Gerente de Vendas e Marketing da Camfil, lista os níveis de risco de cada tipo …
-

Manutenção e Operação
Respeito às normas é fundamental para a eficiência dos sistemas
A Covid-19 colocou no centro da mesa a questão da qualidade do ar que respiramos em ambientes …
-
Automação
QAI e sustentabilidade: dois temas críticos
Atualmente, em nossa visão, existem dois grandes temas muito críticos e latentes que todo novo projeto deve …
-
Manutenção e Operação
É preciso seguir as recomendações dos fabricantes para o bom funcionamento do sistema
Nos últimos três anos a crise sanitária mundial afetou consideravelmente diversos setores da cadeia produtiva, incluindo a …
-

Comissionamento e TAB
Atenção na qualidade do ar interno gerará novas demandas
A pandemia da Covid-19 tem sido um assunto é bastante dinâmico, a cada semana aparecem novas informações …
-

Projeto e Consultoria
O futuro da qualidade do ar interno
A pandemia da Covid-19 trouxe à baila a discussão sobre a responsabilidade de profissionais e empresas com …
-

Eventos
ENTRAC 2022 volta a ser presencial
O ENTRAC – Encontro Tecnológico de Refrigeração e Ar-Condicionado, evento itinerante organizado pela Nova Técnica Editorial, volta …
-

Eventos
XXII SANNAR – Salão Norte-Nordeste de Ar-Condicionado e Refrigeração
O SANNAR – Salão Norte-Nordeste de Ar-Condicionado e Refrigeração, volta a ser presencial após dois anos de …
-
Eventos
Perspectivas econômicas e oportunidades para o AVAC-R é o tema do Abrava de Portas Abertas 2022
Cenário Econômico de 2021 e 2022, oportunidades de negócios, Normas Regulamentadoras e capacitação são temas do encontro …
-

Climatização
Novo produto Gree
A Gree Electric Appliances, acaba de lançar o G-Diamond, aparelho desenvolvido com tecnologia avançada e design exclusivo …
-

Automação
Relevância das válvulas de balanceamento e controle
O sistema de bombeamento de água em processos de AVAC é responsável por boa parte do consumo …
-

Eficiência Energética
Sistemas eficazes no controle da QAI
Em um sistema de climatização as disciplinas de elétrica e automação, além de serem irmãs univitelinas, devem, …
-

Automação
Controle e monitoramento favorecem eficiência, qualidade dos ambientes e longevidade das instalações
Houve época em que um sistema de automação era concebido em primeiro lugar visando a comodidade dos …
-

Eficiência Energética
Qualidade do ar interno e eficiência energética
Uma herança “positiva” da Covid-19 é a maior consciência coletiva quanto a necessidade de cuidados com a …
-

Automação
Automação é a grande aliada dos equipamentos de AVAC-R
O projeto de automação visa a criação de estratégias de controle e supervisão que sejam capazes de …
-

Qualidade do Ambiente Interno
Grupo K1 adquire purificadores de ar ativos
A Dannenge International, através da Mercato Automação, forneceu purificadores ativos de ar produzidos pela RGF Environmental para …
-

Qualidade do Ambiente Interno
PNQAI elege diretoria
No dia 25 de novembro, as entidades participantes do Plano Nacional de Qualidade do Ar Interno (PNQAI), marcaram presença …
-

Projeto e Consultoria
Importância de um bom projeto de ar-condicionado para a qualidade de vida das pessoas foi o centro do XXI ENPC
O Encontro Nacional de Empresas Projetistas e Consultores da Abrava (ENPC), que se encontra em sua …
-

Eventos
Festa de premiação organizada pela Smacna Brasil reúne dezenas de profissionais
O dia 11 de novembro foi especial para o setor do AVAC-R. Em primeiro lugar porque após …
-

Eventos
Principal encontro técnico científico do AVAC-R foi vitorioso
O ano que caminha para seu final foi o segundo em que vivemos com as limitações impostas …
-

Projeto e Consultoria
Smacna organiza jantar com apoio do DNPC durante o Conbrava
No último dia do ENPC, 23 de novembro, a diretoria da Smacna ofereceu um jantar a profissionais …
-

Gestão empresarial
Confraternização pela qualidade do ar interno
Aproveitando a realização do Conbrava e do ENPC, as empresas Conforlab, Ecoquest e Sicflux realizaram no dia …
-
Qualidade do Ambiente Interno
Novo modelo de purificador ativo
A Dannenge International, apresenta o novo modelo de purificador ativo do ar Halo-Rove, uma solução versátil para …
-
3 Revista
Midea lança novo modelo de ar-condicionado inteligente
A Midea anuncia o lançamento do novo modelo de ar-condicionado Xtreme Save Connect, que traz mais tecnologia …
-
Qualidade do Ambiente Interno
Ecoquest discute soluções sustentáveis na construção civil
Estimular o mercado e fortalecer cadeias de produção sustentáveis na construção civil foio objetivo da 1ª Feira …
-

Qualidade do Ambiente Interno
Novos purificadores de ar
Uma unidade autônoma de tratamento do ar de interiores, operando por centrifugação líquida refrigerada, é o lançamento …
-

Qualidade do Ambiente Interno
Tauá Aquapark Indoor tem controle de umidade e temperatura
Inaugurado em outubro de 2019 o Tauá Aquapark Indoor é o primeiro, e único até o momento, …
-

Ventilação e Exaustão
Proteção contra os efeitos da salinidade e atenuação acústica são destaque
Na orla da Boca do Rio o Centro de Convenções de Salvador vem para repor o lugar …
-

Eficiência Energética
Realizar o retrofit sem a paralisação do sistema existente foi o grande desafio
Na Anatel a Proclima Engenharia executou o projeto de retrofit sem a paralisação do funcionamento regular da …
-

Climatização
Instalação do Trimais aposta em qualidade do ar com baixo consumo de energia
Com a promessa de ser um novo marco na Zona Norte de São Paulo, o Trimais Place …
-

Qualidade do Ambiente Interno
No Hospital Águas Claras a segurança foi um dos desafios
A cidade de Águas Claras, com cerca de 150 mil habitantes, não tinha nenhum hospital até o …
-

Eficiência Energética
Um novo ícone na paisagem da Faria Lima
O Birmann 32, entregue o ano passado, é um empreendimento Triple A. Concebido em uma torre única …
-

Climatização
Edifício Torre Nações Unidas: planejamento meticuloso garantiu sucesso da obra
O Edifício Torre Nações Unidas foi projetado pelo escritório de arquitetura Aflalo Gasperini e concebido no final dos anos 1980 sendo, à época, um …
-

Climatização
Destaques do ano Smacna: mais oito obras são premiadas
Há mais de um quarto de século a Smacna Brasil criou o prêmio Destaques do Ano. …
-

Eventos
Conbrava se reinventa em meio à pandemia
Vencendo dificuldades, à primeira vista intransponíveis, o Congresso Brasileiro de Refrigeração, Ar-condicionado, Ventilação e Aquecimento (Conbrava) não …
-

Manutenção e Operação
A responsabilidade técnica pelo PMOC
A definição do Responsável Técnico pelo PMOC exige uma certa compreensão de alguns fatores legais que norteiam …
-

Eventos
Assista as palestras do Entrac virtual 2021
A Nova Técnica Editorial promoveu no mês de setembro mais um Encontro Tecnológico de Refrigeração e Ar-Condicionado …
-

Eventos
Conbrava 2021 já está com as inscrições abertas
Entre os dias 23 e 25 de novembro será realizado o XVII Congresso Brasileiro de Refrigeração, Ar-Condicionado, …
-

Qualidade do Ambiente Interno
Sistemas de ar-condicionado em ambientes hospitalares
Ambientes hospitalares e demais centros de saúde exigem atenções especiais relacionadas aos sistemas de ar-condicionado, especialmente visando …
-

Eventos
Global Meeting Dannenge testa a retomada de eventos no AVAC
Realizado entre os dias 16 e 18 de setembro, no Jurerê International, em Florianópolis (SC), o Global …
-

Eventos
ENTRAC: Qualidade e eficiência em instalações de AVAC-R
PROGRAMAÇÃO 29 DE SETEMBRO – 17H30 ÀS 18H30 QUALIDADE DO AR INTERNO O futuro da renovação do ar, Rafael …
-

Eficiência Energética
Qualidade da água é primordial para o bom desempenho
Bruno Bonaldi, engenheiro da Evapco, explica como sistemas de água gelada perdem eficiência e eficácia ao longo …
-

Climatização
Análise e supervisão permanente proporcionam longevidade aos sistemas de AVAC-R
Um sistema de ar-condicionado central tem o tempo de vida útil estimado em 25 anos. Entretanto, a …
-

Manutenção e Operação
PMOC e qualidade do ar em sistemas split – filtração, tomadas de ar, limpeza dos sistemas
Este período de pandemia demonstrou a importância da qualidade do ar que respiramos, independentemente se estamos …
-

Gestão empresarial
Maria Inez Luz assume a liderança comercial da Sicflux
Nascida no Rio Grande do Sul, Maria Inez Luz foi atraída pelos encantos do Nordeste, para …
-
Gestão empresarial
Global Meeting Dannenge 2021
A Dannenge International realizará a 1ª edição do Global Meeting Dannenge 2021, de 16 a 18 de …
-
Eventos
Febrava 2021 terá espaço dedicado à conectividade no AVAC-R
A Febrava chega à sua 22ª edição, já consolidada como um dos maiores eventos do setor de …
-
Climatização
Sistemas de expansão indireta são mais versáteis para a QAI
Na discussão sobre as melhores alternativas para a climatização de ambientes comerciais e edifícios de uso público, …
-

Climatização
Avaliação do ciclo de vida define o tipo de sistema mais indicado
Rafael Dutra, Coordenador de Aplicação da Trane, fala sobre as alternativas para instalações comerciais leves, como lojas …
-

Climatização
Qualidade do ar será determinante na escolha de sistemas
Fernando Bassegio, Gerente Corporativo de Marketing da Trox do Brasil fala sobre as alternativas para instalações comerciais …
-

Automação
IoT: nova fronteira da automação predial
Fundamental em qualquer empreendimento que aspire a conformidade com os mais avançados parâmetros de qualidade e eficiência, …
-
Eventos
Febrava 2021 acontecerá entre 22 e 25 de novembro
Unindo o evento presencial e atividades on-line como webinars e rodadas de negócios, a 22ª edição da …
-

Eventos
Escolha um associado da Abrava
A Associação Brasileira de Refrigeração, Ar Condicionado, Ventilação e Aquecimento (Abrava), entidade máxima do setor AVAC-R no …
-

Eficiência Energética
A pandemia estreita a margem da ação humana sobre os sistemas
Com a criticidade da situação gerada pela pandemia cada vez menos podemos ter falhas humanas no controle …
-

Eficiência Energética
Com um sistema eficiente é possível controlar as variáveis e manter o ambiente seguro
Na atual situação, de pandemia provocada pelo Sars-Cov-2, o sistema de automação tem papel fundamental no controle …
-

Qualidade do Ambiente Interno
Adequadas taxas de renovação do ar são obrigatórias
A pandemia provocada pelo Sars-CoV-2 acendeu diversos alertas e impôs desafios redobrados à humanidade. O mais letal …
-

Eficiência Energética
Recuperadores de energia respondem às necessidades atuais de renovação do ar
Órgãos públicos e instituições em diferentes países recomendavam uma troca do ar interno na faixa de 15 …
-

Qualidade do Ambiente Interno
As experiências do LEQAI
Nosso grupo de pesquisa, LEQAI, Laboratório de Estudos da Qualidade do Ar Interno, do Departamento de Engenharia …
-

Projeto e Consultoria
QAI e eficiência energética: um antigo tema ganha notoriedade
A discussão QAI versus eficiência energética antecede a pandemia. Já discutíamos este tema quando da normatização de …
-

Projeto e Consultoria
É possível conjugar altas taxas de renovação do ar com eficiência energética
Na edição no. 85 de abril passado da revista Abrava+Climatização & Refrigeração, na matéria Pandemia reforça a …
-

2 Intro
Quanto menor a concentração de particulados, menor a possibilidade de contaminação
Na luta contra as doenças transmitidas pelo ar, como é o caso da Covid-19, faz-se necessário que, …
-

Qualidade do Ambiente Interno
Soluções hospitalares da Tosi
As indústrias Tosi oferecem duas soluções para hospitais e estabelecimentos assistenciais de saúde, particularmente indicados para estes …
-

Qualidade do Ambiente Interno
A valorização das tecnologias para o tratamento do ar
Em um webinário recente promovido pela Abrava, o médico, pesquisador e professor titular da cadeira de patologia …
-

1 Destaques
Covid-19: oportunidade para a valorização da QAI
As grandes crises, em geral, são portadoras de oportunidades. Entretanto, não raro as chances de significativos avanços …
-

2 Intro
O mercado pós-pandemia exigirá mais especialização do profissional de AVAC-R
É quase consensual que a percepção acerca da qualidade dos ambientes climatizados por usuários, gestores e proprietários …
-

Comissionamento e TAB
Definição de escopo do comissionamento
No momento atual de desenvolvimento de processos de qualidade construtiva e de instalações prediais e industriais, muito …
-

Qualidade do Ambiente Interno
Produtos e serviços para QAI
O mercado tem bons fornecedores de produtos e serviços para a Qualidade do Ar Interno. Conheça alguns …
-

Qualidade do Ambiente Interno
Esforço do Qualindoor para disseminar o conceito de QAI
Marcelo Munhoz, presidente, Leonardo Cozac e Henrique Cury, membros fundadores do Qualindoor, listam algumas ações do organismo …
-

Conservação de Alimentos
O AVAC-R é uma atividade essencial, inclusive para conter o Sars-CoV-2
Após intervenção direta do Departamento Jurídico da Abrava, o setor AVAC-R foi considerado enquanto atividade essencial, pela legislação federal, desde …
-

Qualidade do Ambiente Interno
Pandemia reforça a necessidade de obediência às normas em projetos de climatização
Quinze meses após o primeiro caso detectado, em Wuhan, China, a covid-19 apresenta dados assustadores. No dia …
-

Qualidade do Ambiente Interno
Recomendações para a operação de sistemas de AVAC
As providências de caráter operacional que as entidades recomendam são majorar em 25% a vazão de ar …
-

Qualidade do Ambiente Interno
As responsabilidades da indústria da climatização frente à pandemia
O novo coronavírus impõe mudanças de hábitos em todas as esferas da vida cotidiana. O setor de …
-

Qualidade do Ambiente Interno
A valorização das práticas de operação e manutenção em sistemas de climatização
Se os projetistas de climatização sempre respeitaram em suas especificações as normas e regulamentações que regem a …
-

Gestão empresarial
Troca de comando na Daikin
Roberto Yi é o novo presidente da Daikin no Brasil. O executivo, formado em Administração de Empresas …
-

Qualidade do Ambiente Interno
Purificadores de Ar Blue Life
A linha Blue Life de Purificadores da Trox foi especialmente projetada e desenvolvida para ambientes que possuem …
-

4 Home
Midea apresenta produtos eficientes
A pandemia trouxe, como elemento adicional, a necessidade da economia de energia. No home office, por exemplo, …
-
Gestão empresarial
Tecnologias ativas contra vírus e bactérias
“As tecnologias para manter a qualidade do ar já existem há algum tempo, mas víamos maior utilização …
-
Qualidade do Ambiente Interno
Novo sistema de purificação de ar portátil da Carrier
A Carrier apresenta o SafeAir, sistema de purificação de ar portátil. O modelo é capaz de remover …
-
Gestão empresarial
Ecoquest prepara-se para o “novo normal”
Espaços comerciais, sobretudo hotéis e restaurantes, que recebem muitos clientes e com grande rotatividade, terão que se …
-

Vídeos
Do sonho da medicina à qualidade do ar interno
Quando menina, Ana Carolina de Souza Rodrigues sonhava ser médica. “É uma profissão bonita. Os profissionais da …
-

Climatização
Projeto de renovação para cada tipo de produto
A climatização deve estar de acordo com as necessidades de conforto térmico de um ser humano, em …
-

Climatização
Ventiladores externos: uma necessidade
O técnico deve entender que splits não possuem sistema de renovação de ar e que, portanto, é …
-

Automação
A crescente relevância da automação e a integração dos sistemas
É impossível pensar o mundo sem automação. Ao adentrarmos o estacionamento de um shopping center ou hipermercado, …
-

Climatização
O que o técnico precisa observar para a correta instalação de sistemas split
Os equipamentos de expansão direta, tipo split e minisplit, têm impulsionado o mercado mundial de ar-condicionado; entretanto, …
-

Qualidade do Ambiente Interno
Associação buscou interação com as várias entidades com sinergia com o AVAC-R
Segundo Arnaldo Basile, presidente executivo da Abrava, a associação que representa o setor AVAC-R gerou muito conteúdo …
-

Qualidade do Ambiente Interno
Setor ofereceu respostas rápidas e eficientes para a pandemia
De conjunto, e mundialmente, o setor do AVAC-R reagiu bem às exigências apresentadas pela sociedade para restringir …
-

Climatização
Para ser eficiente, cada sistema de tratamento de águas exige um programa específico
Antes de falarmos sobre o tratamento de águas precisamos entender sua função no Planeta, assim como reconhecer …
-

Qualidade do Ambiente Interno
O AVAC-R soube reagir muito bem ao Sars-CoV-2
O presidente executivo da Abrava faz um balanço de como as empresas de refrigeração e ar-condicionado, e …
-

Qualidade do Ambiente Interno
Taxas de renovação do ar e uso das rodas entálpicas
Bo Andersson, diretor da Heatex, notou a preocupação de alguns empreendedores com a relação de recuperadores de …
-

Qualidade do Ambiente Interno
Controle de renovação de ar com sensores de CO2
Quando falamos de ambientes com ar-condicionado, principalmente ambientes de uso público e coletivo, um item está ganhando …
-
Gestão empresarial
Esterilização UV-C
A Meister Safe, empresa que se propõe entregas soluções individualizadas de esterilização de ambientes por meio de …
-

Gestão empresarial
Purificador de ar da Gree
A Gree anuncia o lançamento do purificador de ar Hunter, aliado à saúde no cenário aberto pela …
-

Gestão empresarial
Nova caixa plenum compacta
A Trox acaba de apresentar a caixa plenum compacta AK6C. Segundo fontes da empresa, o produto garante …
-

Qualidade do Ambiente Interno
Benefícios da IEQ para as empresas
O consultor Marcos Antonio Vargas Pereira, diretor da Térmica Brasil, tem se dedicado a estudar os benefícios …
-
Qualidade do Ambiente Interno
Assaí Atacadista investe em qualidade do ar
A Ecoquest, empresa com mais de 14 anos de atividades voltadas à qualidade do ar em ambientes …
-

Automação
Tecnologias de descontaminação e controle das variáveis
O conforto ambiental compreende o estudo das condições térmicas, acústicas, luminosas e energéticas e os fenômenos físicos …
-

Qualidade do Ambiente Interno
O investimento em pessoas é rentável para toda a sociedade
O conceito de qualidade do ar interno (indoor air quality) tem sido crescentemente ampliado para o de …
-

Qualidade do Ambiente Interno
Microclimatização, ventilação personalizada e desacoplamento entre cargas com escalonamento energético
Segundo o Manual ASHRAE GreenGuide, os termos Qualidade Ambiental Interior (IEQ) e Qualidade do Ar Interior (IAQ) …
-

Conteúdo Patrocinado
Tosi aumenta seu portfólio de soluções para a qualidade do ar e para a geração simultânea de água quente e gelada
A recuperação dos negócios já tem refletido nos negócios das Indústrias Tosi. E em setores que, há …
